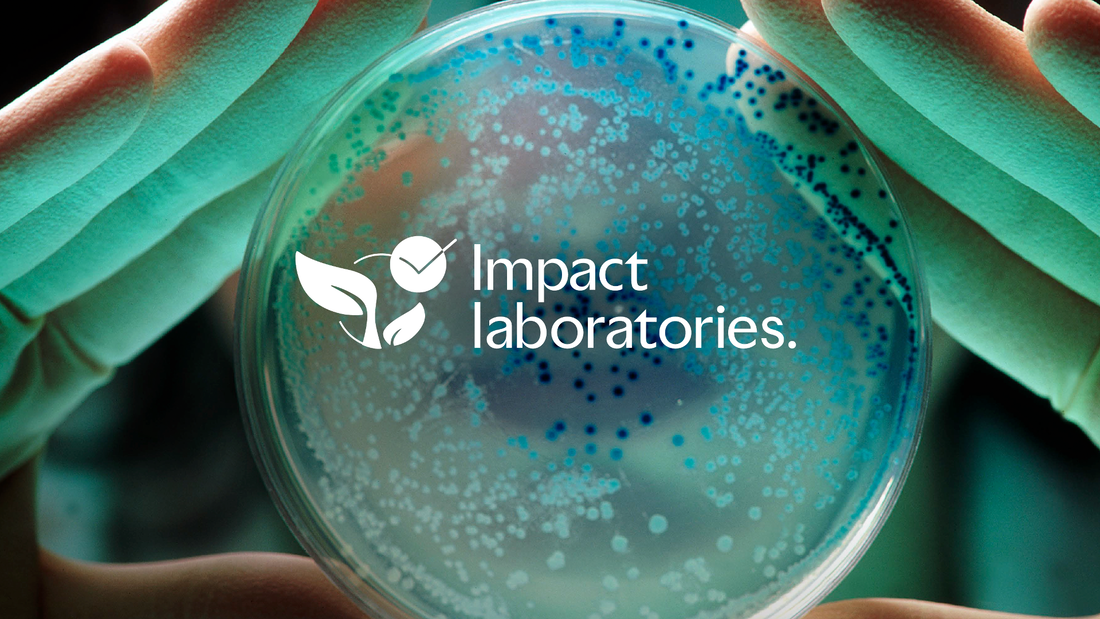
Petri dish with Impact Laboratories logo in white

The celebration of Earth Day serves as a reminder for us to reflect on our relationship with the planet and the impact of our actions. Every facet of our lives intertwines with the environment, both personally and professionally. In the laboratory, where innovation and scientific advancement take center stage, our impact may often go unnoticed.

In 2023, My Green Lab and the broader green lab community achieved notable milestones, bringing sustainability to the forefront of the scientific community. From unprecedented program expansions to launching a global collective supply chain initiative, My Green Lab’s mission and momentum continues to grow; supported by a powerful and dedicated community of green lab leaders around the world.



This report released during COP28 shows an increase in the sector's Race to Zero commitments while highlighting the need for increased action in scope 3 reductions and collaborative supply chain engagement

As most scientists and lab experts would agree, laboratories demand substantial resources and have a considerable ecological footprint. To put it in perspective, labs generate an astonishing 12 billion pounds (5.5 billion kg) of plastic waste annually and consume ten times the energy and four times the water compared to typical office spaces.

While many scientists have embraced the idea that environmental responsibility is paramount, it can seem daunting to actually implement sustainability best practices within a lab space. From research and development (R&D) to healthcare diagnostics and everything in between, labs are essential for worldwide knowledge acquisition and advancement.

Join us in welcoming Dulan Liyanage to team My Green Lab! An MEng graduate from the University of Manchester, Dulan is a travel aficionado with a passion for sales and sustainability. He recently joined the team as Market Development Representative.


